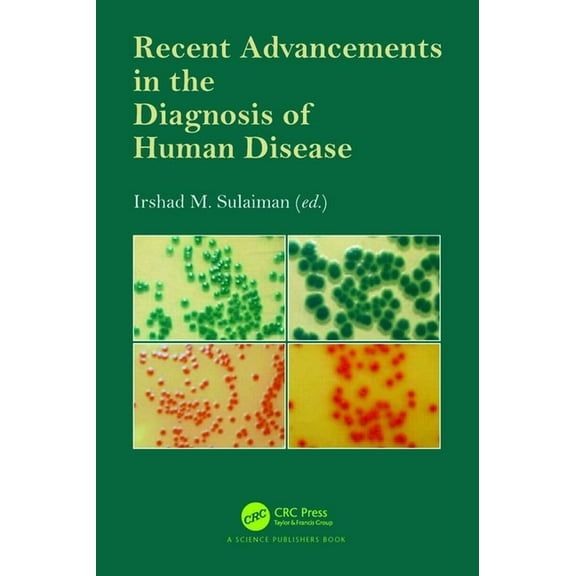
Recent Advancements in the Diagnosis of Human Disease, (Hardcover)

Andrews' Diseases of the Skin: Clinical Dermatology, (Hardcover)
(No ratings yet)
Key item features
- Andrews' Diseases of the Skin: Clinical Dermatology, (Hardcover)
- Author: Elsevier
- ISBN: 9780323878708
- Format: Hardcover
- Publication Date: 2024-11-07
- Page Count: 1032
Specs
- Book formatHardcover
- Fiction/nonfictionNon-Fiction
- GenreTextbooks
- Pub date2025-01-01
- Pages1032
- SubgenreDermatology
Current price is USD$159.39
Price when purchased online
- Free shipping
Free 30-day returns
How do you want your item?
Columbus, 43215
Arrives by Thu, Feb 5
|Sold and shipped by HealthScience&Technology
4.612903225806452 stars out of 5, based on 31 seller reviews(4.6)31 seller reviews
Free 30-day returns
More seller options (2)
Starting from $159.39
About this item
Product details
Through thirteen superb editions, Andrews' Diseases of the Skin has remained the reference of choice for core information in dermatology for residency through clinical practice. The fully revised 14th Edition of this award-winning title continues the tradition of excellence with new tools and strategies for diagnosis and treatment, new entities and newly recognized diseases, increased coverage of skin of color, new videos, and more. It's the reference you'll turn to again and again when faced with a clinical conundrum or therapeutically challenging skin disease.
- Utilizes a concise, clinically focused, user-friendly format that clearly covers the full range of common and rare skin diseases. The small team author approach provides consistency and clearly conveys the authors' first-hand experience
- Features expanded coverage of skin of color-now 46% of all images-including distinct distribution or presentations, how to recognize disease states, and how treatment responses may differ
- Works in tandem with the companion Andrews' Diseases of the Skin Clinical Atlas, 2nd Edition, which contains over 3,000 images-one-third of which are skin of color images
- Offers outstanding visual support with more than 1,500 illustrations-more than one-third are of skin of color, and more tables and figures to help compare genetic syndromes
- Provides access to more than 20 videos online, depicting venous lake treatment using long-pulsed Nd: YAG laser, chemical peels, Q-switched laser tattoo removal, ED&C (electrodesiccation and curettage), nerve block, and more
- Includes up-to-date coverage of monoclonal antibodies; new cosmetic treatment modalities; new tools in the diagnosis and treatment of lymphoma; new staging, diagnostic modalities, and treatment for melanoma and non-melanoma skin cancers; and new treatment paradigms for hair disorders
- Keeps you current with newly defined genetic syndromes, environmental changes and alterations in infectious disease states and heat- and cold-related conditions; new contact allergens; new devices such as the 1726 nm laser for acne intervention; and new molecular investigative techniques
- Covers new biologics for psoriasis, atopic dermatitis, itch and hidradenitis suppurativa, and JAK inhibitors for alopecia area and vitiligo, with decision grids to help choose the appropriate drug for each patient
- An eBook version is included with purchase. The eBook allows you to access all of the text, figures, and references, with the ability to search, customize your content, make notes and highlights, and have content read aloud. Additional digital ancillary content may publish up to 6 weeks following the publication date
- Andrews' Diseases of the Skin: Clinical Dermatology, (Hardcover)
- Author: Elsevier
- ISBN: 9780323878708
- Format: Hardcover
- Publication Date: 2024-11-07
- Page Count: 1032
info:
We aim to show you accurate product information. Manufacturers, suppliers and others provide what you see here, and we have not verified it.
Specifications
Book format
Hardcover
Fiction/nonfiction
Non-Fiction
Genre
Textbooks
Pub date
2025-01-01
Warranty
Warranty information
Please be aware that the warranty terms on items offered for sale by third party Marketplace sellers may differ from those displayed in this section (if any). To confirm warranty terms on an item offered for sale by a third party Marketplace seller, please use the 'Contact seller' feature on the third party Marketplace seller's information page and request the item's warranty terms prior to purchase.
Compare with similar items
| Product | Viewing this itemAndrews' Diseases of the Skin: Clinical Dermatology, (Hardcover)  $159.39 current price $159.39 | New Clinical Applications: Dermatology Treatment in Dermatology, Book 4, (Hardcover)  $199.17 current price $199.17 | Immunology of the Skin: Basic and Clinical Sciences in Skin Immune Responses, (Hardcover)  Now $200.74 current price Now $200.74, Was $219.99$219.99 | Practical Clinical Microbiology and Infectious Diseases: A Hands-On Guide, (Hardcover)  $200.30 current price $200.30 | Basic and Clinical Dermatology Wound Healing, Book 34, (Hardcover)  Now $215.29 current price Now $215.29, Was $251.81$251.81 | Andrews' Diseases of the Skin Clinical Atlas, (Hardcover)  $208.80 current price $208.80 | Current Clinical Oncology Myeloma Bone Disease, (Hardcover)  $199.59 current price $199.59 | Dermatology in Pediatrics, (Hardcover)  $131.00 current price $131.00 | Microbiology with Diseases by Body System, (Hardcover)  $184.48 current price $184.48 | Treatment of Skin Diseases: A Practical Guide (Hardcover)  Now $131.72 current price Now $131.72, Was $157.00$157.00 |
|---|
| Book format | HardcoverAndrews' Diseases of the Skin: Clinical Dermatology, (Hardcover) | HardcoverNew Clinical Applications: Dermatology Treatment in Dermatology, Book 4, (Hardcover) | HardcoverImmunology of the Skin: Basic and Clinical Sciences in Skin Immune Responses, (Hardcover) | HardcoverPractical Clinical Microbiology and Infectious Diseases: A Hands-On Guide, (Hardcover) | HardcoverBasic and Clinical Dermatology Wound Healing, Book 34, (Hardcover) | HardcoverAndrews' Diseases of the Skin Clinical Atlas, (Hardcover) | HardcoverCurrent Clinical Oncology Myeloma Bone Disease, (Hardcover) | HardcoverDermatology in Pediatrics, (Hardcover) | HardcoverMicrobiology with Diseases by Body System, (Hardcover) | HardcoverTreatment of Skin Diseases: A Practical Guide (Hardcover) |
|---|---|---|---|---|---|---|---|---|---|---|
| Fiction/nonfiction | Non-FictionAndrews' Diseases of the Skin: Clinical Dermatology, (Hardcover) | Non-FictionNew Clinical Applications: Dermatology Treatment in Dermatology, Book 4, (Hardcover) | Non-FictionImmunology of the Skin: Basic and Clinical Sciences in Skin Immune Responses, (Hardcover) | Non-FictionPractical Clinical Microbiology and Infectious Diseases: A Hands-On Guide, (Hardcover) | Non-FictionBasic and Clinical Dermatology Wound Healing, Book 34, (Hardcover) | Non-FictionAndrews' Diseases of the Skin Clinical Atlas, (Hardcover) | Non-FictionCurrent Clinical Oncology Myeloma Bone Disease, (Hardcover) | Non-FictionDermatology in Pediatrics, (Hardcover) | Non-FictionMicrobiology with Diseases by Body System, (Hardcover) | Non-FictionTreatment of Skin Diseases: A Practical Guide (Hardcover) |
| Genre | TextbooksAndrews' Diseases of the Skin: Clinical Dermatology, (Hardcover) | TextbooksNew Clinical Applications: Dermatology Treatment in Dermatology, Book 4, (Hardcover) | TextbooksImmunology of the Skin: Basic and Clinical Sciences in Skin Immune Responses, (Hardcover) | TextbooksPractical Clinical Microbiology and Infectious Diseases: A Hands-On Guide, (Hardcover) | TextbooksBasic and Clinical Dermatology Wound Healing, Book 34, (Hardcover) | TextbooksAndrews' Diseases of the Skin Clinical Atlas, (Hardcover) | TextbooksCurrent Clinical Oncology Myeloma Bone Disease, (Hardcover) | TextbooksDermatology in Pediatrics, (Hardcover) | TextbooksMicrobiology with Diseases by Body System, (Hardcover) | Health, Mind & BodyTreatment of Skin Diseases: A Practical Guide (Hardcover) |
| Pub date | 2025-01-01Andrews' Diseases of the Skin: Clinical Dermatology, (Hardcover) | 19870331New Clinical Applications: Dermatology Treatment in Dermatology, Book 4, (Hardcover) | 2016-03-25Immunology of the Skin: Basic and Clinical Sciences in Skin Immune Responses, (Hardcover) | 20200929Practical Clinical Microbiology and Infectious Diseases: A Hands-On Guide, (Hardcover) | 2005-01-01Basic and Clinical Dermatology Wound Healing, Book 34, (Hardcover) | -Andrews' Diseases of the Skin Clinical Atlas, (Hardcover) | 2010-05-04Current Clinical Oncology Myeloma Bone Disease, (Hardcover) | -Dermatology in Pediatrics, (Hardcover) | 2017-01-06Microbiology with Diseases by Body System, (Hardcover) | 20230919Treatment of Skin Diseases: A Practical Guide (Hardcover) |
Now hiding additional rows in the Table
Similar items you might like
Based on what customers bought
New Clinical Applications: Dermatology Treatment in Dermatology, Book 4, (Hardcover) $199.17
 $19917current price $199.17
$19917current price $199.17New Clinical Applications: Dermatology Treatment in Dermatology, Book 4, (Hardcover)
Save withShipping, arrives in 3+ daysImmunology of the Skin: Basic and Clinical Sciences in Skin Immune Responses, (Hardcover) $200.74 Was $219.99
 Now$20074current price Now $200.74, Was $219.99$219.99
Now$20074current price Now $200.74, Was $219.99$219.99Immunology of the Skin: Basic and Clinical Sciences in Skin Immune Responses, (Hardcover)
Save withShipping, arrives in 3+ daysPractical Clinical Microbiology and Infectious Diseases: A Hands-On Guide, (Hardcover) $200.30
 $20030current price $200.30
$20030current price $200.30Practical Clinical Microbiology and Infectious Diseases: A Hands-On Guide, (Hardcover)
Save withShipping, arrives in 3+ daysBasic and Clinical Dermatology Wound Healing, Book 34, (Hardcover) $215.29 Was $251.81
 Now$21529current price Now $215.29, Was $251.81$251.81
Now$21529current price Now $215.29, Was $251.81$251.81Basic and Clinical Dermatology Wound Healing, Book 34, (Hardcover)
Save withShipping, arrives in 3+ daysAndrews' Diseases of the Skin Clinical Atlas, (Hardcover) $208.80
 $20880current price $208.80
$20880current price $208.80Andrews' Diseases of the Skin Clinical Atlas, (Hardcover)
Shipping, arrives in 3+ daysCurrent Clinical Oncology Myeloma Bone Disease, (Hardcover) $199.59
 $19959current price $199.59
$19959current price $199.59Current Clinical Oncology Myeloma Bone Disease, (Hardcover)
Save withShipping, arrives in 3+ daysDermatology in Pediatrics, (Hardcover) $131.00
 $13100current price $131.00
$13100current price $131.00Dermatology in Pediatrics, (Hardcover)
Save withShipping, arrives in 3+ daysMicrobiology with Diseases by Body System, (Hardcover) $184.48
 $18448current price $184.48
$18448current price $184.48Microbiology with Diseases by Body System, (Hardcover)
Shipping, arrives in 3+ daysTreatment of Skin Diseases: A Practical Guide (Hardcover) $131.72 Was $157.00
 Now$13172current price Now $131.72, Was $157.00$157.00+$4.98 shipping
Now$13172current price Now $131.72, Was $157.00$157.00+$4.98 shippingTreatment of Skin Diseases: A Practical Guide (Hardcover)
Shipping, arrives in 3+ daysNew Clinical Applications: Dermatology Talking Points in Dermatology - II, Book 6, (Hardcover) $139.97
 $13997current price $139.97
$13997current price $139.97New Clinical Applications: Dermatology Talking Points in Dermatology - II, Book 6, (Hardcover)
Save withShipping, arrives in 3+ daysRecent Advancements in the Diagnosis of Human Disease, (Hardcover) $174.63
$17463current price $174.63
$17463current price $174.63Recent Advancements in the Diagnosis of Human Disease, (Hardcover)
Save withShipping, arrives in 3+ daysInflammatory Diseases: Immunopathology, Clinical and Pharmacological Bases (Hardcover) $171.70
 $17170current price $171.70
$17170current price $171.70Inflammatory Diseases: Immunopathology, Clinical and Pharmacological Bases (Hardcover)
Save withShipping, arrives in 3+ daysBasic and Clinical Dermatology Phototherapy and Photochemotherapy for Skin Disease, (Hardcover) $93.71
 $9371current price $93.71
$9371current price $93.71Basic and Clinical Dermatology Phototherapy and Photochemotherapy for Skin Disease, (Hardcover)
Save withShipping, arrives in 3+ daysThe Autoimmune Diseases, (Hardcover) $225.00
 $22500current price $225.00
$22500current price $225.00The Autoimmune Diseases, (Hardcover)
Shipping, arrives in 3+ daysSkin Diseases in the Immunocompromised, (Hardcover) $169.99
 $16999current price $169.99
$16999current price $169.99Skin Diseases in the Immunocompromised, (Hardcover)
Save withShipping, arrives in 3+ daysContemporary Endocrinology Immunoendocrinology: Scientific and Clinical Aspects, (Hardcover) $210.34
 $21034current price $210.34
$21034current price $210.34Contemporary Endocrinology Immunoendocrinology: Scientific and Clinical Aspects, (Hardcover)
Save withShipping, arrives in 3+ daysImported Skin Diseases, (Hardcover) $153.00
 $15300current price $153.00
$15300current price $153.00Imported Skin Diseases, (Hardcover)
Shipping, arrives in 3+ daysDendritic Cells in Clinical Immunology, (Hardcover) $130.88 Was $155.99
 Now$13088current price Now $130.88, Was $155.99$155.99+$4.98 shipping
Now$13088current price Now $130.88, Was $155.99$155.99+$4.98 shippingDendritic Cells in Clinical Immunology, (Hardcover)
Shipping, arrives in 3+ daysDevelopments in Nephrology Basic, Clinical, and Surgical Nephrology, Book 8, (Hardcover) $196.39
 $19639current price $196.39
$19639current price $196.39Developments in Nephrology Basic, Clinical, and Surgical Nephrology, Book 8, (Hardcover)
Save withShipping, arrives in 3+ daysPulmonary Medicine: Clinical Practice, (Hardcover) $118.89
 $11889current price $118.89
$11889current price $118.89Pulmonary Medicine: Clinical Practice, (Hardcover)
Shipping, arrives in 3+ days
Popular items in this category
Best selling items that customers love
Lookingbill & Marks' Principles of Dermatology, (Paperback) $58.48 Was $66.99
 Now$5848current price Now $58.48, Was $66.99$66.99
Now$5848current price Now $58.48, Was $66.99$66.99Lookingbill & Marks' Principles of Dermatology, (Paperback)
Shipping, arrives in 3+ daysAbdominal Surgery: Clinical Perspectives, (Hardcover) $102.46
 $10246current price $102.46
$10246current price $102.46Abdominal Surgery: Clinical Perspectives, (Hardcover)
Save withShipping, arrives in 3+ daysCambridge Pocket Clinicians Dermatology, (Paperback) $43.44
 $4344current price $43.44
$4344current price $43.44Cambridge Pocket Clinicians Dermatology, (Paperback)
Save withShipping, arrives in 3+ daysBe Not Afraid of Life: In the Words of William James, (Hardcover) $15.89
 $1589current price $15.89
$1589current price $15.89Be Not Afraid of Life: In the Words of William James, (Hardcover)
Save withShipping, arrives in 3+ daysLies I Taught in Medical School (Hardcover) $29.95
 $2995current price $29.95
$2995current price $29.95Lies I Taught in Medical School (Hardcover)
45 out of 5 Stars. 4 reviewsSave withShipping, arrives in 3+ daysProcedures in Cosmetic Dermatology Cosmeceuticals: Procedures in Cosmetic Dermatology Series, (Hardcover) $103.50 Was $119.99
 Now$10350current price Now $103.50, Was $119.99$119.99
Now$10350current price Now $103.50, Was $119.99$119.99Procedures in Cosmetic Dermatology Cosmeceuticals: Procedures in Cosmetic Dermatology Series, (Hardcover)
Shipping, arrives in 3+ daysAdvances in Experimental Medicine and Bi How Helminths Alter Immunity to Infection, Book 828, (Hardcover) $49.82
 $4982current price $49.82
$4982current price $49.82Advances in Experimental Medicine and Bi How Helminths Alter Immunity to Infection, Book 828, (Hardcover)
Save withShipping, arrives in 3+ daysMethods in Molecular Medicine Meningococcal Disease, Book 67, (Hardcover) $106.97
 $10697current price $106.97
$10697current price $106.97Methods in Molecular Medicine Meningococcal Disease, Book 67, (Hardcover)
Save withShipping, arrives in 3+ daysDifferential Diagnoses in Surgical Pathology: Genitourinary System (Hardcover) $182.93
 $18293current price $182.93
$18293current price $182.93Differential Diagnoses in Surgical Pathology: Genitourinary System (Hardcover)
Shipping, arrives in 3+ daysRadical Irish Lives Molecular Genetics of Cancer, (Hardcover) $239.34
 $23934current price $239.34
$23934current price $239.34Radical Irish Lives Molecular Genetics of Cancer, (Hardcover)
Shipping, arrives in 3+ daysHandbook of Neuro-Oncology Neuroimaging, (Hardcover) $178.70
 $17870current price $178.70
$17870current price $178.70Handbook of Neuro-Oncology Neuroimaging, (Hardcover)
Save withShipping, arrives in 3+ daysLiving with Terminal Lung Cancer: A Story of Hope, (Hardcover) $12.13
 $1213current price $12.13
$1213current price $12.13Living with Terminal Lung Cancer: A Story of Hope, (Hardcover)
Save withShipping, arrives in 3+ daysThe William Welby Collection The Naked Truth About Nudism, Book 2, (Hardcover) $18.99
 $1899current price $18.99
$1899current price $18.99The William Welby Collection The Naked Truth About Nudism, Book 2, (Hardcover)
Save withShipping, arrives in 3+ daysNatural Killer Cells: At the Forefront of Modern Immunology, (Hardcover) $133.43
 $13343current price $133.43
$13343current price $133.43Natural Killer Cells: At the Forefront of Modern Immunology, (Hardcover)
Save withShipping, arrives in 3+ daysOrganic Chemistry, (Hardcover) $117.82
 $11782current price $117.82
$11782current price $117.82Organic Chemistry, (Hardcover)
Shipping, arrives in 3+ daysClinical Practice and Post-Infection Care for COVID-19 Patients, (Hardcover) $217.50 Was $435.00
 Now$21750current price Now $217.50, Was $435.00$435.00
Now$21750current price Now $217.50, Was $435.00$435.00Clinical Practice and Post-Infection Care for COVID-19 Patients, (Hardcover)
Save withShipping, arrives in 3+ daysMetallobiology Metal Chelation in Medicine, Book 8, (Hardcover) $142.29
 $14229current price $142.29
$14229current price $142.29Metallobiology Metal Chelation in Medicine, Book 8, (Hardcover)
Save withShipping, arrives in 3+ daysThe Sick Rose: Disease and the Art of Medical Illustration, (Hardcover) $19.99
 $1999current price $19.99
$1999current price $19.99The Sick Rose: Disease and the Art of Medical Illustration, (Hardcover)
Save withShipping, arrives in 3+ daysPrescription for Natural Cures (Third Edition): A Self-Care Guide for Treating Health Problems with Natural Remedies Inc, (Hardcover) $43.45
 $4345current price $43.45
$4345current price $43.45Prescription for Natural Cures (Third Edition): A Self-Care Guide for Treating Health Problems with Natural Remedies Inc, (Hardcover)
Save withShipping, arrives in 3+ daysService Fanatics: How to Build Superior Patient Experience the Cleveland Clinic Way, (Hardcover) $18.40
 $1840current price $18.40
$1840current price $18.40Service Fanatics: How to Build Superior Patient Experience the Cleveland Clinic Way, (Hardcover)
Save withShipping, arrives in 3+ days
Customer ratings & reviews
0 ratings|0 reviews
This item does not have any reviews yet
